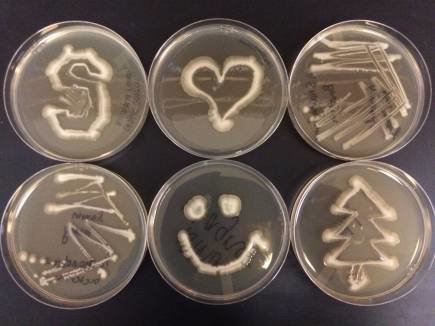
marine bacteria on a "fun" plate

Stanford Earth course takes students to the extremes
New course covering deep sea microbes and outer space draws students from all majors into the study of planet Earth.
In Life at the Extremes: From the Deep Sea to Deep Space, casual banter often involved the possibility of life on other planets – and it was not science fiction. During the fall introductory seminar, offered for the first time in 2016, students learned the basics of microbiology, biochemistry, and astrobiology with the ultimate goal of applying that knowledge to remote places.
“I like to speculate about scientific theories because I’m kind of a sci-fi nerd, but seeing the biological basis for all the stuff I’m speculating about is very interesting,” said freshman Samsara Durvasula, who signed up for the course based on her interest in microbiology. “It just kind of blows my mind most days.”
Durvasula was lucky to be included on the roster – of the 74 students who applied for the course, only 16 were accepted. Geomicrobiologist Anne Dekas designed and taught the new 3-unit course. An assistant professor of Earth system science at the School of Earth, Energy & Environmental Sciences, she said she chose students who asked the most creative questions in their seminar applications. It resulted in a group of freshmen from various backgrounds, including humanities, computer science, and the natural sciences.
“A lot of people have a natural interest in space and the possibility of extraterrestrial life,” Dekas said. “I thought the class would appeal to students with that natural interest while exposing them to a range of environmental sciences, some of which they might decide to study in more depth in the future.”
From labs to the coast
Sharing a variety of her experiences as a geomicrobiologist studying the deep sea, Dekas told stories about her research in submersibles and introduced the class to some of her local collaborators. In one visit to the Monterey Bay Aquarium Research Institute (MBARI), students participated in a private tour of the ROV Doc Ricketts. On another field excursion to NASA’s Ames Research Center, they learned about exoplanet bioastronomy from researcher Tori Hoehler and toured a microbiology lab containing a microbial mat, a lasagna-like structure used to study the dynamics of microbial communities.
“This class opened me up to the STEM field,” said Jason Zheng, a freshman from Santa Cruz, California, referring to the disciplines of science, technology, engineering, and mathematics. “I think the most fascinating thing was learning how microorganisms have almost more agency than larger, more visible creatures.”
The class also spent one day in Dekas’ lab on campus, where they scraped cells from the insides of their mouths and used a microscope to identify bacteria among the human cheek cells. They learned how to grow bioluminescent marine bacteria in single colonies and discovered the properties of bioluminescence in a scene taken from Star Wars.
“To demonstrate that the enzyme that causes bioluminescence requires oxygen, I filled a meter-long tube with a liquid culture of bioluminescent bacteria,” Dekas said. “When you turn the tube upside down, an air bubble goes from the bottom to the top, exposing the bacteria to oxygen and causing them to produce light. Eventually, the entire tube emits a bright greenish-yellow light, sort of like a bacterial light saber.”
Whether through the field trips, lab work, or classroom lectures, students were able to engage with their material in different ways. During one class, Dekas set up a series of rocks collected over different times and left the room while the students examined them for features that indicated liquid water or life. When she returned, the students were gathered on one side of the classroom.
“They serenaded me with a song about rocks they had come up with while I was out of the room,” Dekas said. “They were laughing and so excited about the song – it was just a great moment of how fun learning can be and how into the material they were.”
Thinking beyond Earth
For their final exam, the students presented on the possibility of life on Mars, Titan, Enceladus, or Europa, assessing suitability of the celestial body’s chemistry and habitat, and the history of our exploration. Still, it was not science fiction – the students were required to provide scientific evidence for their hypotheses and graded based on their scrupulous research of both known and unknown factors.
“A lot of astrobiology is speculative, but to speculate you first you need to understand the basics of life on a molecular level, and how it interacts with the environment,” Dekas said. “It requires significant understanding across scientific disciplines.”
Life at the Extremes is the first course Dekas has taught to undergraduates at Stanford and she plans to offer it again in fall 2017. She designed it based on her own interest in cross-disciplinary research and her unorthodox career path. While Dekas knew she wanted to be a scientist in college, she didn’t know what type, she said. Her interest in the integration of different fields eventually led her to pursue Earth sciences.
“Scientific research is challenging, but it’s also fun, and the process of discovery can be deeply rewarding,” Dekas said. “I think it’s important to give students the idea that they can love their job, and if they’re interested in science, they should consider pursuing it.”
Dekas said she hopes to be a resource for her students throughout their college journeys and encourages them to be open-minded in the development of their interests. Durvasula, whose parents are both physicians, started at Stanford with a background in biology from high school. The class has been influential in broadening her perspective of science, including the fieldwork involved with collecting data and the process of writing a scientific paper, she said.
“I came in thinking I wanted to do pre-med, like bioengineering, but I’m thinking now my interests lie more in energy and biofuels,” Durvasula said. “I don’t know where exactly I’ll end up at this point, but the course exposed me to a different side of biology I hadn’t really considered before.”
Zheng, who has not yet declared a major, shared similar sentiments about how the course offered new perspectives. He advised anyone interested in the topic not to be insecure about lacking a background in the life sciences.
“It’s really a nice springboard into figuring out where your interests lie,” said Zheng, who didn’t expect to have an interest in science while he was in high school. “I think the best part about it was that I didn’t need a whole lot of experience to take it and I didn’t feel overwhelmed about not knowing a lot of biology.”
Explore More
-
Scholars including Daniel Neamati, a TomKat Center Graduate Fellow, and Tadashi Fukami, a professor of Earth system science, rely on aerial imagery to enhance their understanding of landscape changes and ecological recovery at at Jasper Ridge Biological Preserve ('Ootchamin 'Ooyakma).
-
Vanorio is the first woman to receive the award, which is presented to a member of the European Association of Geoscientists and Engineers (EAGE) who has made an outstanding contribution to scientific and technical advancement in Petroleum Geoscience and Engineering.



